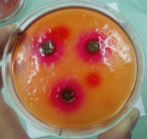

93536 (590122), страница 5
Текст из файла (страница 5)
Насыщенный раствор индикатора в ацетоне. К 0,025г индикатора прибавляют 100мл ацетона и время от времени встряхивают, через час фильтруют [18].
Фенолфталеин.
Переход окраски от бесцветной к красной в пределах рН 8,2-10,0. Раствор индикатора 1г индикатора растворяют в спирте и доводят спиртом до 100мл [18].
Вода дистиллированная. Н2О.М. в.18,02.
Бесцветная прозрачная жидкость без запаха и вкуса. рН от 5,0 до 6,8. Кислотность и щелочность. К 10мл воды прибавляют 1 каплю раствора метилового красного; появляется желтое окрашивание, переходящее в розовое от прибавления не более 0,05мл 0,01н раствора соляной кислоты. Сухой остаток.100мл выпаривают досуха и сушат при 100-105ºС до постоянного веса. Остаток не должен превышать 0,001%.
Хранение. В асептических условиях, в доверху заполненных флаконах, не более 24 часов [18].
2.2 Методы исследования
Приготовление геля и агаровых пластинок
Агаровый гель готовится 2% концентрации в предварительно тарированном стеклянном или эмалированном сосуде, плотно закрытом крышкой. Изрезанный агар (ГОСТ 6470-53) заливается очищенной водой и оставляется на 30 минут для набухания.
Набухший агар нагревается до кипения, доводится до необходимой массы и к теплому гелю добавляется 5% реактива Эрлиха состава: п-диметиламинобензальдегида 0,5г, кислоты хлористоводородной концентрированной и этанола 95% по 15мл и н-бутанола - 90мл.
Приготовленный таким образом агаровый гель разливается в чашки Петри с горизонтальной поверхностью дна (d=98-100мм, h=20мм), которые выставляются на столе, предварительно выверенном по горизонтальному уровню с помощью ватерпаса. Агар разливается в чашки двумя порциями по 10 и 15мл. После застывания агара (первой порции) на ее поверхность, в каждую чашку помещаются три металлических цилиндра (из нержавеющей стали или стекла с наружным диаметром 8мм и высотой до 10мм), и заливается второй слой агара. После застывания агара цилиндрики осторожно вынимаются. И в образовавшиеся углубления (колодцы) помещаются исследуемые образцы мази [20].
Определение скорости высвобождения лекарственных веществ из мази
Мази, содержащие лекарственное вещество с различной степенью дисперсности, помещают в лунки двух чашек с агаром. Чашки нумеруют или указывают степень измельчения. Мазь в лунки переносят с помощью стеклянной палочки, осуществляя контроль за тем, чтобы был хороший контакт с агаром. Мази с плотной или вязкой консистенцией перед использованием следует тщательно растирать или выдержать 30 минут при температуре 30ºС. Чашки помещают в термостат с температурой 37ºС.
Лекарственное вещество высвобождается из мази, диффундирует в агаровый гель, образуя с реактивом окрашенную зону. Через 1-2-3 часа, с помощью линейки (лучше - штангенциркуля) измеряют диаметр окрашенной зоны. В случае необходимости (при образовании эллипса) измеряют больший и меньший диаметр, и определяют среднее значение диаметра окрашенной зоны. Полученные результаты записывают в дневник и подвергают математико-статистической обработке.
Средняя ошибка среднего арифметического вычисляется по формуле
m= ±∑аk,
где:
m - средняя ошибка среднего арифметического диаметров окрашенных зон;
∑ - сумма;
а - цифровые значения отклонений диаметров зон от среднего арифметического со знаком "+" или "-";
k - величина, зависящая от числа вариантов, то есть количества опытов (n) для каждого образца мази. В данном случае равна 0,29004 при n=3 [20].
Определение стабильности
Для проверки стабильности и качества мази использовался метод расслаивания - центрифугирование.
На электронных весах отвешивается по 5г мази с каждой модели, помещая их в пробирки. Пробирки устанавливаем в держатели центрифуги.
На первом этапе таймер центрифуги устанавливается на 10 минут на скорость вращения - 500 об/мин. Через 10 минут вынимаем пробирки и, при достаточном освещении, проверяем мази на расслаивание. В случае изменения однородности мазей - разделения их на отдельные компоненты - производят измерение высоты расслоившихся фракций и описание их по внешнему виду.
На втором этапе таймер устанавливается на 10 минут, а скорость вращения центрифуги - 1000 об/мин. По истечении времени проводят те же действия: замеры, определения, что и на первом этапе. На последующих этапах увеличивают только число оборотов. 2000, 3000 об/мин и т.д. Число оборотов увеличивают до тех пор, пока не произойдет расслаивание во всех взятых мазях. По результатам данного опыта мы можем судить о сравнительной стабильности или нестабильности мазей.
Приготовление индикаторов
Фенолфталеин.1г индикатора растворяют в спирте и доводят спиртом до 200мл [18].
Метилоранж.0,1г растертого индикатора растворяют в воде и доводят водой до 200мл [18].
Бромкрезоловый пурпуровый.1.0,1г растертого индикатора растворяют в 20мл теплого спирта и доводят водой до 100мл.2.0,1г индикатора растирают в ступке с 3,7мл 0,05н. раствора едкого натра и после его растворения доводят свежий прокипяченный и охлажденный водой до 250мл [18].
Бромтимоловый синий.1.0,1г растертого индикатора растворяют в 20мл теплого спирта и после охлаждения доводят водой до 100мл.2.0,1г индикатора растирают в ступке с 3,2мл 0,05н раствора едкого натра и после его растворения доводят свежепрокипяченной и охлажденной водой до 250мл [18].
Судан III.0,1г индикатора растворяем в аммиаке и доводим до 100мл 95% спиртом [18].
Агар (агар-агар).2г агара заливаем 98мл холодной воды, оставляем на 30 минут (для набухания). В течение 15 минут выдерживаем на водяной бане, при температуре около 100ºС. Затем заливаем в чашки Петри и оставляем до полного застывания [18].
3. Технология мазей мумие на основе бентонитовой глины
3.1 Разработка состава мазей мумие на основе бентонитовой глины
Первым этапом работы стал подбор оптимального состава мази мумие на основе бентонитовой глины. Нами были предложены шесть моделей мазей мумие на основе бентонитовой глины. Состав моделей в таблице 1.
Таблица 1 Состав модели мазей мумие на основе бентонитовой глины
| № | Наименование ингредиентов | Номера моделей | |||||
| 1 | 2 | 3 | 4 | 5 | 6 | ||
| Состав, в% | |||||||
| 1 | Мумиё | 7,5 | 7,5 | 7,5 | 7,5 | 7,5 | 7,5 |
| 2 | Вода | 27 | 7 | 7 | 27 | 7 | 7 |
| 3 | Ланолин | 1,1 | 1,1 | 1,1 | 1,1 | 1,1 | 1,1 |
| 4 | Вазелин | 40,5 | 60,4 | 60,4 | 40,4 | 52,4 | 52,4 |
| 5 | Глина белая | 24 | 24 | - | - | 24 | - |
| 6 | Глина голубая | - | - | 24 | 24 | - | 24 |
| 7 | Глицерин | - | - | - | - | 5 | 5 |
Приготовление мазей мумие на основе бентонитовой глины осуществлялось следующим образом: мумие растворяли в воде.
Приготовление основы. Отдельно готовили сплав ланолина и вазелина, затем в сплав добавляли глину при активном перемешивании. При приготовлении моделей № 5 и 6 глицерин добавляли в сплав вазелина и ланолина до добавления глины.
В приготовленную основу частями добавляли раствор мумие в воде.
Выбор состава мази мумиё из предложенных моделей производили по биологической доступности мумиё из моделей мази
Определение биологической доступности полученных моделей мазей мумие на основе бентонитовой глины, по методике описанной в пункте 2.2
В качестве индикаторов использовались слабые растворы судана III, фенолфталеина, метилоранжа, бромкрезолового пурпурового, бромтимолового синего. У судана III, фенолфталеина и бромтимолового синего при взаимодействии с небольшим количеством мумие окраска не изменилась, метилоранж при взаимодействии с мумие помутнел, а бромкрезолово-пурпуровый резко изменил окраску, с грязно-желтого на кроваво-красный.
Таким образом, для определения биологической доступности мази мумие целесообразно использовать бромкрезолово пурпуровый, так как при добавлении его в агар мы получаем четкую картину дифузии мумие в агар (рис.2), нежели при использовании метилоранжа (рис.3).
Рисунок 2 - Диффузия мумие из мази на основе бентонитовой глины в агар-агар с индикатором бромкрезолово-пурпуровым
Рисунок 3 - Диффузия мумие мази на основе бентонитовой глины в агар-агар с индикатором метилоранжем
Результаты исследований биологической доступности мази мумие представлены в таблице 2.
Таблица 2 Высвобождение действующего вещества из лекарственной формы
| Модель мази время в мин. | 1 | 2 | 3 | 4 | 5 | 6 |
| 30 | 1 - 12 мм 2 - 14 мм 3 - 13 мм | 1 - 7 мм 2 - 7 мм 3 - 7 мм | 1 - 7 мм 2 - 7 мм 3 - 7 мм | 1 - 11 мм 2 - 12 мм 3 - 12 мм | 1 - 9 мм 2 - 9 мм 3 - 10 мм | 1 - 9 мм 2 - 9 мм 3 - 8 мм |
| 60 | 1 - 15 мм 2 - 16 мм 3 - 15 мм | 1 - 7 мм 2 - 7 мм 3 - 7 мм | 1 - 7 мм 2 - 7 мм 3 - 7 мм | 1 - 12 мм 2 - 12 мм 3 - 12 мм | 1 - 11 мм 2 - 10 мм 3 - 10 мм | 1 - 11 мм 2 - 11 мм 3 - 9 мм |
| 120 | 1 - 23 мм 2 - 20 мм 3 - 21 мм | 1 - 7 мм 2 - 7 мм 3 - 7 мм | 1 - 7 мм 2 - 7 мм 3 - 7 мм | 1 - 18 мм 2 - 20 мм 3 - 20 мм | 1 - 12 мм 2 - 11 мм 3 - 10 мм | 1 - 12 мм 2 - 12 мм 3 - 10 мм |
| 180 | 1 - 23 мм 2-22,5мм 3 - 22 мм | 1 - 7мм 2 - 7 мм 3 - 7 мм | 1 - 7 мм 2 - 7 мм 3 - 7 мм | 1 - 23 мм 2 - 24 мм 3 - 23 мм | 1 - 15 мм 2 - 15 мм 3 - 13 мм | 1 - 16 мм 2 - 15 мм 3 - 14 мм |
Анализируя данные таблицы 2 можно сделать вывод, что действующее вещество не высвобождается из моделей 2 и 3, где в состав основы входит глицерин, тогда как в остальных моделях происходит высвобождение действующего вещества. На рисунках 4 и 5 представлены результаты исследования высвобождения действующего вещества из мазей 2 и 3 по истечении 3 часов. В связи с этим использование такой основы не целесообразно и производить дальнейшие исследования этих двух моделей бесперспективно.
модель мази 2
Рисунок 4 - Результат исследования биологической доступности мази мумие с добавкой глицерина к бентонитовой основе (модель 2)
модель мази 3